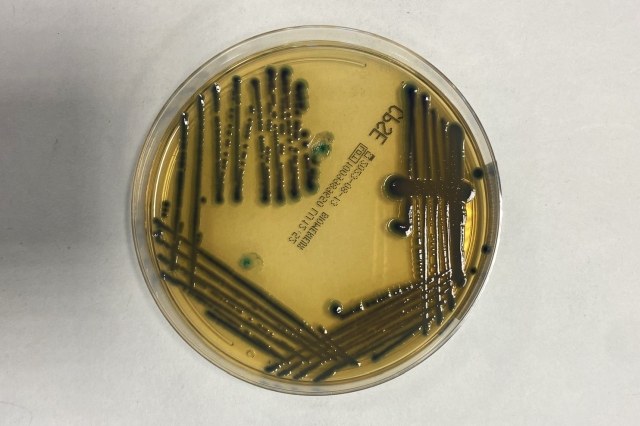

Crescita di colture batteriche in vitro
Un sistema di intelligenza artificiale basato sull’apprendimento automatico per scoprire i principali elementi – tra fattori clinici, biochimici e di virulenza – che predicono un esito avverso per i pazienti colpiti da sepsi. Con un’attenzione particolare per le infezioni del torrente circolatorio da Klebsiella pneumoniae, uno dei patogeni più pericolosi in ambito medico.
Lo realizzerà un nuovo progetto di ricerca PRIN (Progetti di Rilevante Interesse Nazionale), finanziato dal Ministero dell’Università, a cui partecipa anche l'Università di Bologna con il Dipartimento di Fisica e Astronomia "Augusto Righi". Guidato dalla Microbiologia della Romagna, diretto dal professor Vittorio Sambri, insieme anche all'Università di Catania, il progetto consentirà di studiare più di 500 isolati batterici di Klebsiella pneumoniae.
I ceppi batterici saranno sottoposti a sequenziamento e ad analisi bioinformatiche. E i dati ottenuti saranno poi integrati con parametri clinici e biochimici, grazie all’ausilio di sistemi di intelligenza artificiale dal Gruppo di Biofisica dell'Università di Bologna, guidato dal professor Daniel Remondini.
Klebsiella pneumoniae è un batterio che colonizza normalmente il tratto intestinale dell’uomo. Ha la capacità di acquisire materiali genetici esterni che gli consentono di modulare il proprio potere patogeno e di resistere agli antibiotici. L’epidemiologia di questo patogeno è complicata inoltre dall’emergere in Italia di cloni ipervirulenti. Ad oggi, sono stati identificati più di cento distinti geni di resistenza antimicrobica e nuovi fattori di virulenza sono stati scoperti recentemente. Queste caratteristiche ne fanno uno dei patogeni più pericolosi in ambito medico, soprattutto per quanto riguarda le infezioni del paziente fragile correlate all’assistenza.
A questo si collega il tema della sepsi: una condizione in cui una grave infezione si diffonde in tutto il corpo che oggi è una delle principali cause di morte al mondo tra i ricoverati nelle unità di terapia intensiva, tanto che l'Organizzazione Mondiale della Sanità l'ha recentemente inclusa tra le priorità sanitarie globali. Proprio per questo gli studiosi hanno deciso di focalizzare il progetto sulle infezioni del torrente circolatorio, che sono gravate da un'elevata mortalità.